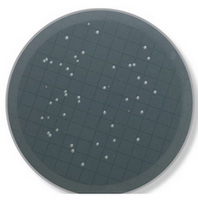

實驗室試劑
實驗室耗材
實驗室安全產品
微生物監控
實驗室儀器
水質環保監控
大氣監控
產品簡介:EZ-Pak®全自動弧形取膜器特點新一代全自動取膜器無菌膜快速分配操作無需接觸膜片單手轉移表面。設備耐用設備經久耐用,容量大,每次最多可安裝150片膜安裝簡易新型保護蓋設計,只需30秒就可安裝完成。膜片放置位…







| 綠膜 | 白膜 | 黑膜 | |
| 應用 | 瓶裝水、啤酒中的細菌 | 通用 | 霉菌,酵母菌,軍團菌 |
| 檢測 | 透明、半透明的菌落 | 所有微生物 | 白色或米黃色菌落 |
| 直徑 | 47mm 和50mm | 47mm 和50mm | 47mm 和50mm |
|
結構材料 |
玻璃珠增強尼龍6 |
|
滾軸材料 |
聚甲醛(POM) |
|
外形(長×寬×高)cm |
18×31×16.5 |
|
重量 |
2.15 kg |
|
電池 |
14.8 V充電鋰離子電池 |
|
安全 |
2004/108/EC: Electromagnetic compatibility 2006/95/EC: Electrical security2011/65/EC: RoHS PSE |
|
詳細描述 |
數量/包裝 |
貨號 |
|
EZ-Pak®全自動弧形取膜器 |
1 | EZCURVE01 |
|
EZ-Pak®全自動弧形取膜器(外接電源), 無電池 |
1 | EZCURVEAC |
| 詳細描述 | 數量/包裝 | 貨號 |
|
鋰離子電池 |
1 | EZCURVBAT |
|
電源適配器(用于外接電源型取膜器) |
1 | EZCURVPOW |
|
電源適配器(用于內置電池型取膜器) |
1 | EZCURVCHA |
|
滾軸夾子 |
2 | EZCURVCLI |
|
螺絲刀(用于暴露膜的調整) |
1 | EZCURVSCR |
| 顏色 | 孔徑(μm) | 直徑(mm) | 數量/包裝 | 貨號 |
| 白色 | 0.22 | 47 | 4 盒 x 150 片 | EZGS WG4 74 |
| 白色 | 0.45 | 47 | 4 盒 x 150 片 | EZHA WG4 74 |
| 白色 | 0.45 | 50 | 4 盒 x 150 片 | EZHA WG5 04 |
| 白色 | 0.7 | 47 | 4 盒 x 150 片 | EZHC WG4 74 |
| 白色 | 0.8 | 47 | 4 盒 x 150 片 | EZAA WG4 74 |
| 綠色 | 0.45 | 47 | 4 盒 x 150 片 | EZHA GG4 74 |
| 綠色 | 0.45 | 50 | 4 盒 x 150 片 | EZHA GG5 04 |
| 黑色 | 0.45 | 47 | 4 盒 x 150 片 | MSPO 008 14 |
| 黑色 | 0.45 | 50 | 4 盒 x 150 片 | EZHA BG5 04 |
| 黑色 | 0.8 | 47 | 4 盒 x 150 片 | EZAA BG4 74 |
| 顏色 | 孔徑(μm) | 直徑(mm) | 數量/包裝 | 貨號 |
| 白色 | 0.22 | 47 | 100 ml 濾杯 | MZGS WG1 01 |
| 白色 | 0.45 | 47 | 100 ml 濾杯 | MZHA WG1 01 |
| 白色 | 0.8 | 47 | 100 ml 濾杯 | MZAA WG1 01 |
| 黑色 | 0.45 | 47 | 100 ml 濾杯 | MZHA BG1 01 |
| 黑色 | 0.8 | 47 | 100 ml 濾杯 | MZAA BG1 01 |
| 白色 | 0.45 | 47 | 250ml 濾杯 | MZHA WG2 51 |
| 白色 | 0.8 | 47 | 250 ml 濾杯 | MZAA WG2 51 |
| 黑色 | 0.45 | 47 | 250ml 濾杯 | MZHA BG2 51 |
|
EZ-Stream™ 真空隔膜泵 |
EZSTREAM1 |
|
三頭Microfil®過濾底座和EZ-Fit™支架 |
EZFITMIC03 |
|
單頭Microfil®過濾底座和EZ-Fit™支架 |
EZFITMIC01 |